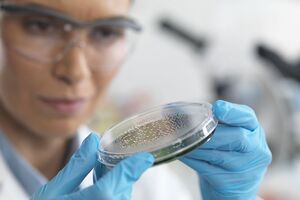

Os animais são um (grande) negócio
A faturação das clínicas aumentou 46% em dois anos – os donos procuram mais e melhores tratamentos e há grupos económicos que dominam o mercado.

A faturação das clínicas aumentou 46% em dois anos – os donos procuram mais e melhores tratamentos e há grupos económicos que dominam o mercado.

Fazem fortunas a vendê-los (a mais de €2.000 cada), mas também os usam para a captura ilegal do ouriço-cacheiro. Muitos morrem, outros apanham sarna e carraças. A GNR registou 59 crimes deste tipo, desde o início de 2025 até 26 de maio – a incidência é maior nos distritos de Lisboa e de Beja.

Mais de 40 entidades assinam uma carta aberta alertando para as "graves consequências" da transferência da tutela dos animais de companhia e errantes do Ministério da Agricultura para o do Ambiente.

Donos dos animais fugiram devido a um atraso de pagamento do aluguer da habitação, no Brasil.

Número de cães abatidos é quase o dobro do número de animais tratados em sete anos.
Foi descoberta uma molécula com potencial para curar a doença do sono, a Chagas e a leishmanio se - juntas, matam 50 mil pessoas por ano, mas afastam as farmacêuticas. Porquê?

Acusação é da organização humanitária não governamental curda Crescente Vermelho

Maus-tratos animais continuam a dar que falar no país.